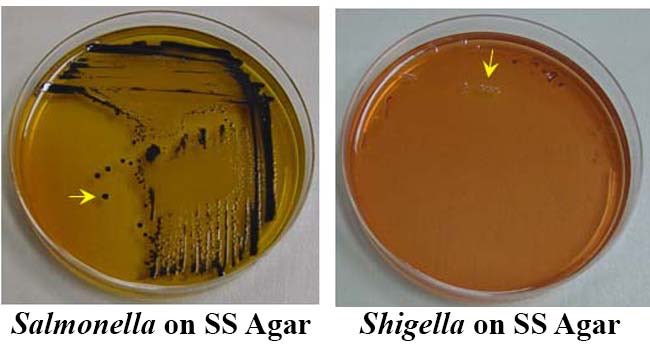
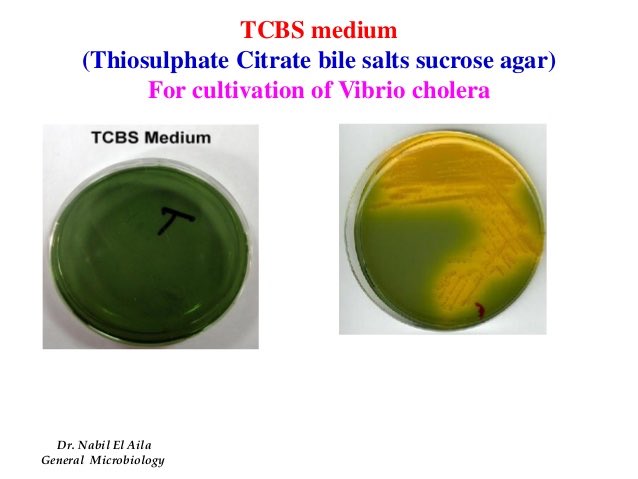
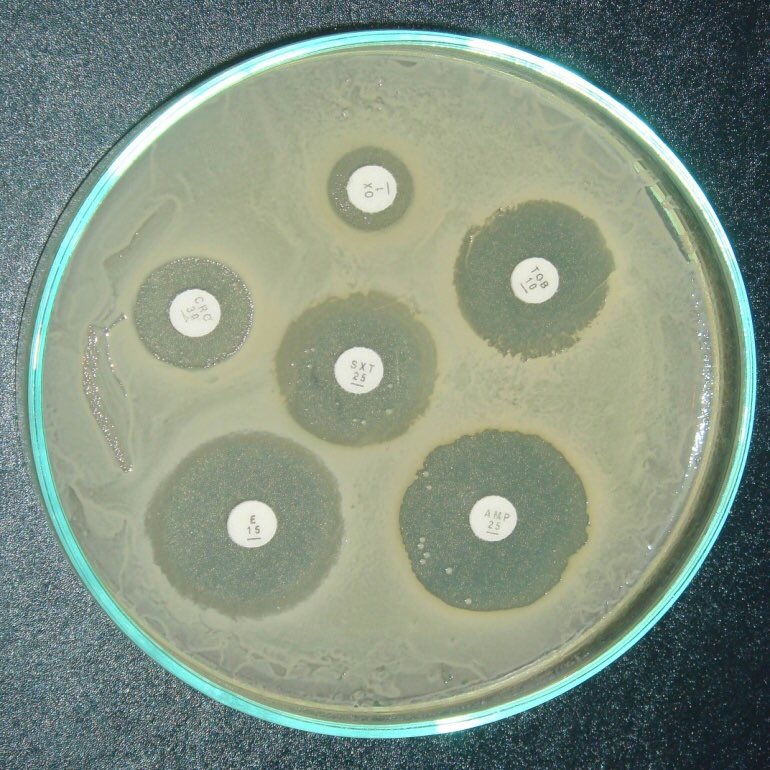

?أنواع الأوساط الغذائية ( Culture Media) المستخدمة في الميكروبيولوجيا وخصائص كلاً منها ?:
#فريق_الأحياء_التطوعي
@BioVolunteers
#فريق_الأحياء_التطوعي
@BioVolunteers
3-MacConkey Agar
• بيئة تفريقية للتفريق بين البكتيريا
المخمرة للاكتوز (Lactose fermenting)
والتي تأخذ اللون الأحمر مثل
E.coli, Klebsiella, Enterobacter
وبين البكتيريا الغير مخمرة للاكتوز
(Non -lactose fermenting)
والتي ليس لها لون (شفاف) مثل
Proteus, Salmonella,Shigella
• بيئة تفريقية للتفريق بين البكتيريا
المخمرة للاكتوز (Lactose fermenting)
والتي تأخذ اللون الأحمر مثل
E.coli, Klebsiella, Enterobacter
وبين البكتيريا الغير مخمرة للاكتوز
(Non -lactose fermenting)
والتي ليس لها لون (شفاف) مثل
Proteus, Salmonella,Shigella
4- ( CLED agar)اختصار ل
Cystine Lactose electrolyte deficient
• وسط لزراعة عينات الجهاز البولي.
• بيئة تفريقية للتفريق بين البكتيريا :
المخمرة للاكتوز (Lactose fermenting)
والتي تأخذ اللون الأصفر مثل E.coli .
Cystine Lactose electrolyte deficient
• وسط لزراعة عينات الجهاز البولي.
• بيئة تفريقية للتفريق بين البكتيريا :
المخمرة للاكتوز (Lactose fermenting)
والتي تأخذ اللون الأصفر مثل E.coli .
6-(SS Agar) اختصار ل
Salmonella - Shigella agar
• بيئة اختيارية لا تسمح بنمو البكتيريا الموجبة لصبغة جرام وبعض البكتيريا السالبة لصبغة جرام ماعدا
Salmonella and Shigella
بسبب وجود
sodium citrate and bile salts and Brilliant Green
Salmonella - Shigella agar
• بيئة اختيارية لا تسمح بنمو البكتيريا الموجبة لصبغة جرام وبعض البكتيريا السالبة لصبغة جرام ماعدا
Salmonella and Shigella
بسبب وجود
sodium citrate and bile salts and Brilliant Green
7-(Mannitol salt Agar (MSA
• بيئة تفريقية للتفريق بين Staphylococcus species و Staphylococcus aureus التي تخمر المانيتول بتأثيرها على لون الكاشف
Phenol Red وتعطي اللون الأصفر
بينما الـ Staph الأخرى لا تخمر المانيتول .
• بيئة تفريقية للتفريق بين Staphylococcus species و Staphylococcus aureus التي تخمر المانيتول بتأثيرها على لون الكاشف
Phenol Red وتعطي اللون الأصفر
بينما الـ Staph الأخرى لا تخمر المانيتول .
جاري تحميل الاقتراحات...